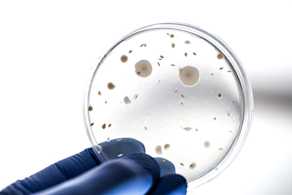

Explore our testing solutions
We offer a comprehensive range of testing solutions for different industries and materials. Explore some of the highlights of our catalog on this page – or contact us to get a quote for tests that are tailored to your needs.

Popular solutions

Medical device packaging testing

Semiconductor testing services

PFAS testing services

Fire testing & classification services

Food contact material testing services

Microplastics testing

Medical device testing services

Packaging testing services

Tested by Measurlabs

Toy safety testing

Events & webinars

IMO 2010 FTP Code fire tests

Measurlabs in the USA

Environmental analysis services

Product inspection services

Construction material testing services

Toxicological evaluation of medical devices

Testing for CE marking

Chemical testing services

Mechanical testing services

Food testing services

UL 94 testing for plastic flammability rating

Routine testing services

Measurlabs customer portal

Textile testing services

Biomass testing services

Testing of engineering plastics

Fuel testing services
Microbiological testing services

Biocompatibility kick-off meeting

Mycotoxin testing

Nanomaterial analysis services
+ hundreds more. Ask us for more information!
Ask for an offer
Fill in the form, and we'll reply in one business day.
Have questions or need help? Email us at info@measurlabs.com or call our sales team.